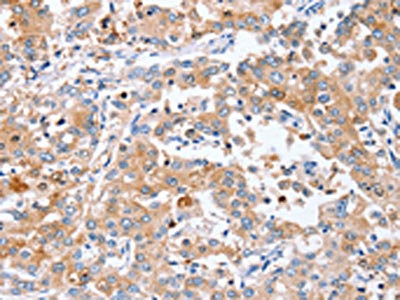

PPOX Antibody
-
中文名稱:PPOX兔多克隆抗體
-
貨號:CSB-PA118443
-
規格:¥1100
-
圖片:
-
其他:
產品詳情
-
Uniprot No.:
-
基因名:PPOX
-
別名:MGC8485 antibody; PPO antibody; PPOX antibody; PPOX_HUMAN antibody; Protoporphyrinogen oxidase antibody; V290M antibody; Variegate porphyria antibody; VP antibody
-
宿主:Rabbit
-
反應種屬:Human,Mouse
-
免疫原:Synthetic peptide of Human PPOX
-
免疫原種屬:Homo sapiens (Human)
-
標記方式:Non-conjugated
-
抗體亞型:IgG
-
純化方式:Antigen affinity purification
-
濃度:It differs from different batches. Please contact us to confirm it.
-
保存緩沖液:-20°C, pH7.4 PBS, 0.05% NaN3, 40% Glycerol
-
產品提供形式:Liquid
-
應用范圍:ELISA,IHC
-
推薦稀釋比:
Application Recommended Dilution ELISA 1:2000-1:5000 IHC 1:50-1:200 -
Protocols:
-
儲存條件:Upon receipt, store at -20°C or -80°C. Avoid repeated freeze.
-
貨期:Basically, we can dispatch the products out in 1-3 working days after receiving your orders. Delivery time maybe differs from different purchasing way or location, please kindly consult your local distributors for specific delivery time.
-
用途:For Research Use Only. Not for use in diagnostic or therapeutic procedures.
相關產品
靶點詳情
-
功能:Catalyzes the 6-electron oxidation of protoporphyrinogen-IX to form protoporphyrin-IX.
-
基因功能參考文獻:
- the regulation of PPOX gene expression can also occur through a post-transcriptional modulation of the amount of gene product and this modulation can be mediated by 5' untranslated exon 1. PMID: 27667166
- GAPDH and protoporphyrinogen oxidase were shown to have higher expression in faster growing cell lines and primary tumors. Pharmacologic inhibition of GAPDH or PPOX reduced the growth of colon cancer cells in vitro PMID: 25944804
- Variegate porphyria is the result of decreased protoporphyrinogen oxidase activity. Diet supplementation with vitamins E and C restores PPOX gene expression in lymphocytes of variegate porphyria patients. PMID: 23601071
- in the hepatic cancer tissue of two acute porphyria patients, somatic second-hit mutations result in nearly complete inactivation of PPOX and HMBS PMID: 25445397
- The c.851G>T and the c.1013C>G of PPOX gene were found in two and four unrelated families respectively. 1 experienced only photosensitivity, 1 only neurological symptoms and the 2 both clinical manifestations. PMID: 19656455
- The mutation 1082-1083insC(1 base pair insertion at position 1082) in exon 10 of the PPOX gene was prevalent in the Swiss population. PMID: 19656457
- findings emphasize the usefulness of MLPA analysis as a complement to PPOX gene sequencing analysis for comprehensive genetic diagnostics in patients with variegate prophyria PMID: 23324528
- VP-causing mutation affect the catalytic activity of hPPO by affecting the ability of hPPO to sample the privileged conformations PMID: 23467411
- sequenced 27 members of a family with variegate porphyria with a T>A transversion at the intron 6 consensus splicing site in 8 patients and 4 SNPs: c.-414A>C; IVS2+121G>C; c.1188G>A and IVS12+34C>T PMID: 19229653
- data deliver further confirmation that the South African and Dutch variegate porphyria families carrying mutation p.R59W shared a common ancestor. PMID: 21910705
- Forty-seven variegate porphyria-causing mutations were purified by chromatography and kinetically characterized in vitro. PMID: 21048046
- Two previously undescribed mutations were identified: PPOX1423-1426-delATCT and PPOX2272insG. PMID: 12017191
- This enzyme in its regular and mutagenized forms is targeted to mitochondria when transfected. PMID: 12556518
- Information required for targeting to the mitochondria is contained within the first 250 amino acid residues of human PPOX. PMID: 14535846
- Modulation of penetrance by the wild-type allele in dominantly inherited erythrohepatic and acute hepatic porphyrias was studied using PPOX. PMID: 14669009
- Protoporphyrinogen oxidase targeting mechanism to the mitochondrion. PMID: 16621625
- Mutation in protoporphyrinogen oxidase is associated with variegate porphyria PMID: 16947091
- GATA-1 binding sites in exon 1 constitute key regulatory elements in differential expression of PPOX in erythroid and non-erythroid cells. PMID: 18191920
顯示更多
收起更多
-
相關疾病:Variegate porphyria (VP)
-
亞細胞定位:Mitochondrion inner membrane; Peripheral membrane protein; Intermembrane side.
-
蛋白家族:Protoporphyrinogen oxidase family
-
組織特異性:Expressed in heart, brain, placenta, lung, liver, skeletal muscle, kidney and pancreas.
-
數據庫鏈接:
Most popular with customers
-
-
YWHAB Recombinant Monoclonal Antibody
Applications: ELISA, WB, IHC, IF, FC
Species Reactivity: Human, Mouse, Rat
-
Phospho-YAP1 (S127) Recombinant Monoclonal Antibody
Applications: ELISA, WB, IHC
Species Reactivity: Human
-
-
-
-
-